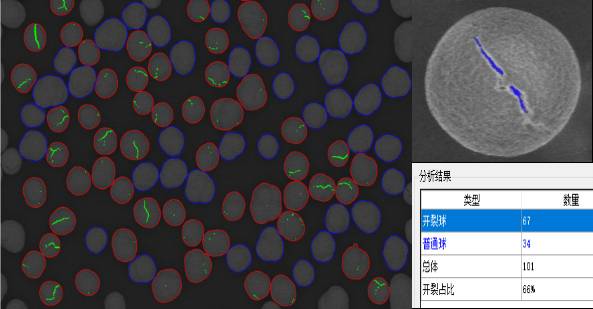

北京欧波同光学技术有限公司
金牌会员
已认证

北京欧波同光学技术有限公司
金牌会员
已认证
欧波同集团长期从事光镜、电镜领域的微观分析工作,通过和广大客户的交流,我们发现现在客户的微分析存在效率低、人的主观因素影响大、非标准化等问题,为此我们成立了汇鸿科技公司,利用智能化软件实现显微分析的自动化、标准化。
一、锂离子电池材料显微智能分析系统(LIBMAS)
锂离子电池是指以锂离子嵌入化合物为电极材料电池的总称,它主要依靠锂离子在正极和负极之间移动来工作。由于材料加工过程中的缺陷,锂电池在使用或储存过程中仍会出现一定概率的失效[1],例如,多孔电极在充放电过程中发生体积膨胀和收缩,导致颗粒逐渐出现裂纹,这些裂纹沿着原有缺陷萌生和扩展,导致材料出现机械断裂和电极结构解体,造成电极材料粉化。这些材料的失效严重降低了锂电池的使用性能,影响其使用的可靠性和安全性。
图一:汇鸿锂离子电池显微智能分析系统
针对锂电池使用过程中产生的各种失效问题,汇鸿智能科技为客户量身定制了专属软件,满足客户所有需求,采用先进AI技术及图像处理技术,可快速准确进行单晶团聚识别、开裂球识别、二次球颗粒分布均匀性判断、截面孔隙统计、隔膜孔隙统计等锂电池材料分析。
1)识别:
通常在制备三元正极材料时,采用共沉淀法[2]使纳米级一次粒子团聚堆积成球形二次粒子,但这种堆积结构容易形成裂纹,导致电池性能衰减。
图二:软件智能区分开裂球和普通球
通过汇鸿LIBMAS,可快速统计并计算开裂球占比,获得开裂球裂缝信息,从而改善工艺条件,如图二。
正极颗粒内部通常是二次球颗粒形成的多晶结构,我们将二次球颗粒抛开,发现循环充放电后的颗粒截面出现大量裂痕,如图三。使用LIBMAS对截面孔隙进行识别,快速获得截面孔隙结果。

图三:二次球截面孔隙识别
2)团聚体颗粒识别:
正极三元颗粒通常需要在高温纯氧下进行烧结,烧结而成的三元产品一般具有典型的团聚体形貌,即由粒径约几百纳米的一次粒子组成的,在几个到十几个微米之间的二次球颗粒。以往采用人工统计分析,需要在SEM成像后,手动逐个测量,工作量大,而且存在人为测量的误差;采用汇鸿智能分析软件,则可以一键操作,简化流程,在短时间内快速获得标准化的统计结果,如图四。
图四:一次颗粒团聚形成的二次球颗粒识别
电极材料的颗粒尺寸影响电池的容量、倍率性能和循环性能[3]。小尺寸颗粒可以缩短锂离子固相扩散路径,内部多孔颗粒可以提供更多的锂离子迁移通道。但是粒径过小会导致库仑效率和充填密度低下,影响整体电池的容量。通过汇鸿LIBMAS可高效识别一次颗粒大小(长、宽、周长、面积等)以及分布情况,如图五。
图五:软件自动区分团聚颗粒及团聚颗粒截面
3)单晶颗粒识别:
相对于单独的纳米粒子,团聚体颗粒具有比表面积小,颗粒流动性好,压实密度高和电极浆料可加工性好等优点。然而在团聚体反复充放电过程中,电极不断膨胀和收缩,内部颗粒十分容易破碎。相比易产生颗粒粉碎的多晶正极材料,许多研究[4,5]已经开始从晶体结构本身出发,探究单晶三元正极材料的性能,结果表明单晶三元具有更好的机械强度,从而抑制颗粒破碎,在高温循环方面也具有更好的热稳定性。诸如此类的研究都需要准确识别出单晶颗粒及其内部分布情况,汇鸿科技LIBMAS可以自动识别团聚颗粒中轮廓清晰的单晶颗粒,并测量、统计其直径,如图六。
图六:单晶颗粒的识别
4)大小二次球识别:
除此之外,汇鸿LIBMAS还可以精准识别图像上所有大二次球颗粒与小颗粒,根据面积判断计算大颗粒与小颗粒分布的均匀性。如图七。

图七:大小二次球颗粒分布均匀性识别和统计
5)隔膜孔隙率统计:
锂电池隔膜作为锂电池的重要组成部分,是具有纳米级微孔结构的高分子功能材料,其主要功能是防止两极接触而发生短路,同时使电解质离子通过。相关研究证实[6],隔膜的微孔孔径分布越均匀,电池的电性能越优异。
孔径的分布主要采用扫描电子显微镜( SEM) 进行观测,但仅靠肉眼观测图片,对孔隙率的表征存在一定误差且效率低下。因此,若要更准确形象地获得材料的孔隙率,需要将图像处理软件与SEM 结合,以实现隔膜孔隙分布及其定量分析的需求。

图八:隔膜孔隙识别及孔隙率统计
汇鸿LIBMAS可以快速获取隔膜的孔隙率信息,检测隔膜孔隙率、孔隙直径及纤维直径并统计分析,从而形象地描述隔膜表面的结构细节,提高锂电池隔膜孔隙率评定的准确性,如图九。
二、锂离子电池异物分析系统(LIBIAS)
目前行业对锂电正极材料中金属及磁性异物的分类主要有以下三个方面:金属及非金属大颗粒、磁性异物、Cu/Zn单质[7]。异物引入的方式有原材料带入和制造过程中产生。为了有效控制锂离子电池正负极材料中非金属/金属/磁性异物的含量,一般会使用专业的设备与软件对初筛后的原材料中异物颗粒进行形貌与成分统计。行业内以往使用光镜或手动测量的方法,然而这些传统检测方式往往在数据结果的准确性、全面性、一致性上有或多或少的不足,给精确检测带来比较大的挑战。目前,锂电池材料中异物颗粒的检测主要面临的问题有:1)异物来源广、溯源难,2)数据量大、费时费力,3)颗粒易团聚、识别难度高。

图一:同一颗粒分别在光学显微镜(左)、电子显微镜(右)下的图像及EDS能谱识别颗粒主要成分为Fe
图二:电镜图像下滤膜上所有颗粒分布情况

图三:滤膜上的颗粒团聚现象
针对传统软件的不足,欧波同集团旗下的汇鸿科技公司开发了“锂离子电池异物分析系统”(LIBIAS)。这是集准确、高效和易操作功能为一体的全自动清洁度分析系统,可以实现高清BSE图像采集拍摄和图像处理、元素定量测试等功能。包括:1)简易上手的测试程序,2)开放的标准库编辑系统,3)一键生成对应报告图表。
图四:颗粒类型占比饼状图(左),三元统计相图(右)
汇鸿智能科技是一家专注于工业领域微观智能图像分析应用解决方案服务商。以“坚持原创,用信息技术引领工业分析”为愿景,可以为用户提供全场景的锂电池智能化显微分析解决方案。汇鸿智能科技研发的”锂离子电池材料显微智能分析系统(LIBMAS)”和“锂离子电池异物分析系统(LIBIAS)”,将高分辨性能的扫描电镜与智能化的分析软件相结合,解决从锂电原材料,到正负极极片、隔膜,锂电清洁度全系列的锂离子电池相关分析,助力研究人员开发出性能更优越的锂电产品。
参考文献:
[1] Wang Qi-Yu, Wang Shuo, Zhou Ge, Zhang Jie-Nan, Zheng Jie-Yun, Yu Xi-Qian, Li Hong. Progress on the failure analysis of lithium battery. Acta Phys. Sin., 2018, 67(12): 128501. doi: 10.7498/aps.67.20180757.
[2] doi.org/10.1016/j.powtec.2009.12.002
[3] 杨绍斌,梁正. 锂离子电池制造工艺原理与应用[M].
[4] science.org/doi/abs/10.1126/science.abc3167.
[5] 肖建伟, 刘良彬, 符泽卫, 等. 单晶LiNixCoyMn1-x-yO2 三元正极材料研究进展[J]. 电池工业, 2017, 21(2): 51-54.
[6] 毛继勇,许汉良.锂离子电池用隔膜孔隙率对电池性能的影响[J].广州化工,2018,46( 14) : 78-80.
[7] 惠升,詹永丽,黎江.锂电正极材料金属及磁性异物过程控制的研究[J].世界有色金属,2021(17):166-168.
作者:沈宁
单位:欧波同
个人简介:沈宁,OPTON创新研究中心BD工程师 ,硕士毕业于上海大学纳米化学与生物学研究所,主要研究方向为石墨烯量子点及其修饰物的应用,期间负责研究所内透射电镜/扫描电镜的使用,培训和维护,硕士期间参与发表四篇专利,两篇SCI学术论文。现负责欧波同集团锂电行业应用市场的开发,对设备选型、技术应用、市场需求有着丰富的经验。
相关产品
更多
相关文章
更多
技术文章
2026-03-27技术文章
2025-10-16技术文章
2025-09-29技术文章
2025-04-12
请拨打厂商400电话进行咨询
使用微信扫码拨号